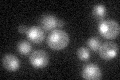
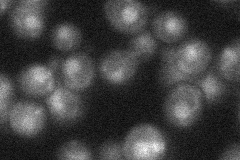
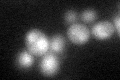

View description
Transcriptional activator of proline utilization genes, constitutively binds PUT1 and PUT2 promoter sequences and undergoes a conformational change to form the active state; has a Zn(2)-Cys(6) binuclear cluster domain
Localization:
Intensity:
Fold change:
Significance:
-
C’ GFP library in SD
nucleus21.52 -
N' NOP1pr-GFP in SD

nucleus58.91 -
N' TEF2pr-mCherry in SD

nucleus70.9143 -
N' NATIVEpr-GFP in SD
nucleus23.7101 -
N' TEF2pr-VC and Cyto-VN in SD

nucleus32.6333 -
C’ GFP library in SD+DTT
nucleus20.320.94No -
C’ GFP library in SD+H2O2

nucleus24.191.12No -
C’ GFP library in Starvation Media

nucleus16.880.78Yes -
C’ GFP library on the background of Pup2-DaMP

nucleus -
C’ GFP library on the background of CCT mutant

nucleus25.79451.19804No
